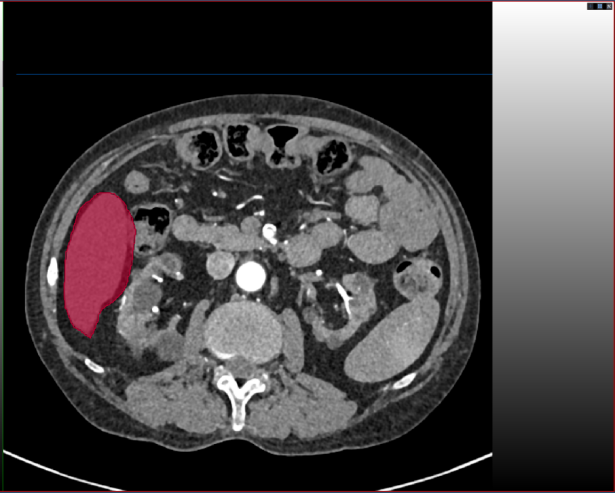

文件格式及命名
1.1原始数据存放规则
对于所有的每个病例数据,放在一个父文件夹下面,这里我放在images这个文件夹下:

每个病例下,必须四哥期的数据同时存在,且文件格式保持一致,即每例病人的四期对应的数据均以“.nii.gz”格式存在,如下图:

1.2标注数据存放格式
这里,按照不同的标注要求来命名(要求突出标注目标),比如此次标注的目标是肝肿瘤,可将每个病例的标注文件夹的父文件夹命名为livertumor_labels:

在livertumor_labels文件夹下面,包含各个病例标注对应的文件夹。以livertumor_labels这个文件夹为例,打开后的内容应该是:

于每个标注病例,里面的内容包括四个期的肿瘤标注文件,每个文件的命名必须和原始图像的命名保持一致。比如原始图像/images/1000001435-2023-07-20文件夹下A.nii.gz文件对应的标注路径应该在/livertumor_labels/1000001435-2023-07-20/A.nii.gz

MITK安装及使用
MITK安装
S
t
e
p
1
:
解压
Z
i
p
文件
Step 1: 解压Zip文件
Step1:解压Zip文件
S
t
e
p
2
:
打开
M
I
T
K
安装包
Step 2: 打开MITK安装包
Step2:打开MITK安装包

S
t
e
p
3
:
安装
M
I
T
K
Step 3: 安装MITK
Step3:安装MITK



MITK标注
Step 1: 打开MITK,双击桌面的MITK图标

Step 2: 导入图像。即手动将亟待标注的”.nii.gz”文件拖动到下图区域

Step 3: 调节窗宽窗位。有两种方式,手动设置及滑动调节。如果标注肝肿瘤,我手动将窗宽窗位调节到[40-400]

Step 4 进入一个窗口进行标注: 进入单个视图画面更大,更有利于标注。

如果标注完成也可退出此视图:

Step 5: 创建分割。这里需要注意,对create segmentation之后的文件进行重命名操作,具体实现看图片文字说明:

Step 6: 执行标注。按照图片的指示进行操作

点击之后可以进行标注了,这个地方可选择的标注工具比较多,下图框出部分即为标注相关工具,标注者需要进行摸索尝试一下!需要用什么标注工具,选择一下即可,然后在图上进行标注及修改

标注示例
下面我进行标注一层进行展示,以更快学习使用,还是分步骤实现吧!(以标注肝脏为例子)
Step 1:点击标注工具add

Step 2:沿着标注目标边缘勾勒
以看到我的勾勒超出肝脏区域了,此外标注的颜色太浓会影响我对标注边界的判断。所以需要对标注进行:1)淡化标注颜色;2)修改标注。
针对问题1,调节标注颜色透明度:

针对问题2:点击下图按钮,然后沿着超出边界部分边缘进行勾画即可消除超出区域(注意:如果是标注不足,则是点击add,对不足区域的边缘进行勾画即可补上不足区域)

修改后的标注如下图所示:

尽管上图标注看似不错,但仍可以进一步精细修改。鼠标指向标注目标区域,按住鼠标右键进行放大

精修后的可视化如图:

接下来,需要对每个切片进行逐层标注,上面仅仅标注第372层切片面,标注者需要对每个切片逐一标注,切换切片的方式为:点击框图中的上下切片切换按键即可

标注完成后,需要对标注文件进行保存:鼠标右键点击此处,选择Save选项


2.4 错误示例

在精修时可能会出现上面的两种情况,一定要仔细检查,切不可马虎。上图中可以看见边缘标注仍然不够完美,所以需要标注者有耐心,避免重复修改!!!


























 2万+
2万+

 被折叠的 条评论
为什么被折叠?
被折叠的 条评论
为什么被折叠?








